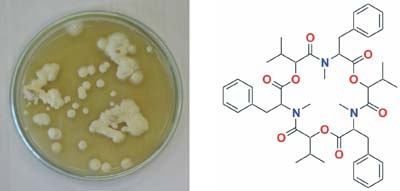
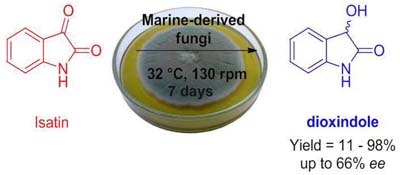

vol. 28, No. 6, 2017, p. 927-1144
This review deals with the chemistry of the sesquiterpenoid alkaloids, a relatively small group of natural products but with outstanding properties, structures and relevance. We couple this text with our respects for the premature disappearance of Angelo da Cunha Pinto, our colleague who came perhaps from Tras dos Montes, and loved to make much fun of all of us while teaching us how to be very involved in all aspects of organic chemistry. First, he dedicated himself to natural products chemistry, and later came round to appreciating their synthesis. Details are presented in the Review The Chemistry of the Sesquiterpene Alkaloids by Timothy J. Brocksom, Kleber T. de Oliveira and André L. Desiderá on page 933.
The Chemistry of the Sesquiterpene Alkaloids
Timothy J. Brocksom; Kleber T. de Oliveira; André L. Desiderá
How to cite this article
This review deals with the chemistry of the sesquiterpenoid alkaloids, a relatively small group of natural products but with outstanding properties, structures and relevance. We couple this text with our respects for the premature disappearance of Angelo da Cunha Pinto, our colleague who came perhaps from Tras dos Montes, and loved to make much fun of all of us while teaching us how to be very involved in all aspects of organic chemistry. First, he dedicated himself to natural products chemistry, and later came round to appreciating their synthesis. Details are presented in the Review The Chemistry of the Sesquiterpene Alkaloids by Timothy J. Brocksom, Kleber T. de Oliveira and André L. Desiderá on page 933.
https://dx.doi.org/10.21577/0103-5053.20170049
Review J. Braz. Chem. Soc. 2017, 28(6), 927-932
Silver and Silver Chloride Nanoparticles and their Anti-Tick Activity: a Mini Review
Nelson Durán; Marcela Durán; Celso E. de Souza
How to cite this article

Silver nanoparticles can act against ticks or against major pathogens transmitted by the bite of ticks such as bacteria, viruses or protozoa with equal or better efficacy of antibiotics, antiviral or antiparasitic agents.
https://dx.doi.org/10.21577/0103-5053.20170045
J. Braz. Chem. Soc. 2017, 28(6), 933-942
The Chemistry of the Sesquiterpene Alkaloids
Timothy J. Brocksom; Kleber T. de Oliveira; André L. Desiderá
How to cite this article

This review presents the structures, biological activities, biosynthesis, and syntheses of the sesquiterpene alkaloids, principally the dendrobine and guaipyridine groups.
This paper is part of the PubliSBQ Special Issue in honor of the late Prof Angelo da Cunha Pinto.
https://dx.doi.org/10.21577/0103-5053.20170049
Articles J. Braz. Chem. Soc. 2017, 28(6), 943-949
Calcium Phosphate Coatings by Sol-Gel on Acrylonitrile-butadiene-styrene Substrate
Lucimara C. Bandeira; Beatriz M. de Campos; Katia J. Ciuffi; Eduardo J. Nassar; Jorge V. L. Silva; Marcelo F. Oliveira; Izaque A. Maia
How to cite this article

The sol-gel methodology affords materials with useful properties for application in biological medium. Additive manufacture is an effective technology to produce complex macrostructures. In combination, sol-gel and additive manufacture produce materials with new properties for various applications.
https://dx.doi.org/10.21577/0103-5053.20160244
J. Braz. Chem. Soc. 2017, 28(6), 950-959
A Simple and Fast Method for Magnetic Solid Phase Extraction of Ochratoxin A
Azam Sargazi; Amin Aliabadi; Ali Rahdari; Samin Allahdini-Hesaroiyeh; Massoud Nejati-Yazdinejad; Mostafa Heidari Majd
How to cite this article

Dopamine loaded MNPs were used as an electrostatic sorbent in magnetic solid phase extraction for separation of ochratoxin A.
https://dx.doi.org/10.21577/0103-5053.20160245
J. Braz. Chem. Soc. 2017, 28(6), 960-966
Laccase-Assisted Rapid Synthesis of Colloidal Gold Nanoparticles for the Catalytic Reduction of 4-Nitrophenol
Fang Li; Zheng Li; Chang Zeng; Yonggang Hu
How to cite this article

Gold nanoparticles were rapidly synthesized by using laccase in alkaline medium at ambient conditions, and exhibited high catalytic stability for the reduction of 4-nitrophenol to 4-aminophenol in the presence of NaBH4.
https://dx.doi.org/10.21577/0103-5053.20160246
J. Braz. Chem. Soc. 2017, 28(6), 967-974
In Tube Ultrasonic and Air Assisted Liquid-Liquid Microextraction-Gas Chromatography-Mass Spectrometry Determination: a Novel Method for the Determination of Phthalate Esters in Aqueous Samples
Abolfazl Farahani; Majid Ramezani; Jalal Hassan; Ali Niazi
How to cite this article

In tube ultrasonic and air assisted liquid-liquid microextraction IT-UAA-LLME) method, was developed for the preconcentration of some phthalate esters, prior to their determination using gas chromatography mass spectrometry.
https://dx.doi.org/10.21577/0103-5053.20160247
J. Braz. Chem. Soc. 2017, 28(6), 975-984
Synthesis, Three-Dimensional Structure, Conformation and Correct Chemical Shift Assignment Determination of Pharmaceutical Molecules by NMR and Molecular Modeling
Sirlene O. F. de Azeredo; Edijane M. Sales; José D. Figueroa-Villar
How to cite this article

Synthesis and application of NMR and molecular modeling to confirm the complete structure and the non questionable chemical shift assignment of these products.
https://dx.doi.org/10.21577/0103-5053.20160248
J. Braz. Chem. Soc. 2017, 28(6), 985-994
Isopropyl Octanoate Synthesis Catalyzed by Layered Zinc n-Octanoate
Swami A. Maruyama; Luis Ricardo S. Kanda; Fernando Wypych
How to cite this article

Reusable layered zinc n-octanoate was employed as catalyst in the esterification of octanoic acid with isopropanol, providing high acid to ester conversions.
https://dx.doi.org/10.21577/0103-5053.20160251
J. Braz. Chem. Soc. 2017, 28(6), 995-1002
Direct Incorporation of Ginger and Oregano Antioxidants in Canola Oil
Andressa H. A. Grabsk; Alexandre S. Avincola; Thiago Claus; Carla Porto; Jesuí V. Visentainer; Eduardo J. Pilau
How to cite this article

This is an efficient method of direct extraction/incorporation of antioxidants from oregano and ginger in canola oil using a green extraction process, which is safe for health and contributes to environmental sustainability.
https://dx.doi.org/10.21577/0103-5053.20160252
J. Braz. Chem. Soc. 2017, 28(6), 1003-1013
Larvicidal Activity of Beauveria bassiana Extracts against Aedes aegypti and Identification of Beauvericins
Juliana F. S. Daniel; Andressa A. Silva; Danielle H. Nakagawa; Lívia S. de Medeiros; Mário G. Carvalho; Lucineli J. Tavares; Lucas M. Abreu; Edson Rodrigues-Filho
How to cite this article
The cyclodepsipeptides beauvericins and bassianolide were identified from the Beauveria bassiana extracts. These extracts showed larvicidal activity on 3rd instar of Aedes aegypti.
https://dx.doi.org/10.21577/0103-5053.20160253
J. Braz. Chem. Soc. 2017, 28(6), 1014-1022
Miscellaneous Diterpenes from the Aerial Parts of Plectranthus ornatus Codd
Fábio N. Avila; Francisco C. L. Pinto; Thiciana S. Sousa; Maria Conceiçao M. Torres; Leticia V. Costa-Lotufo; Danilo D. Rocha; Mayron A. de Vasconcelos; Nairley Cardoso-Sá; Edson H. Teixeira; Maria Rose Jane R. Albuquerque; Edilberto R. Silveira; Otília D. L. Pessoa
How to cite this article

Nine diterpenes, including five unknown diterpenes derivatives, were isolated from the aerial parts of cultivated specimens of Plectranthus ornatus. All compounds were assayed against the four human cancer cell lines, and Gram-positive and Gram-negative bacteria strains.
https://dx.doi.org/10.21577/0103-5053.20160255
J. Braz. Chem. Soc. 2017, 28(6), 1023-1029
First Asymmetric Reduction of Isatin by Marine-Derived Fungi
Willian G. Birolli; Irlon M. Ferrreira; David E. Q. Jimenez; Bianca N. M. Silva; Bárbara V. Silva; Angelo C. Pinto; André L. M. Porto
How to cite this article
A screening was carried out and several strains of marine-derived fungi were able to reduce isatin and produced the enantioenriched dioxindole, up to 66% ee and with different conversions (11-98%).
This paper is part of the PubliSBQ Special Issue in honor of the late Prof Angelo da Cunha Pinto.
https://dx.doi.org/10.21577/0103-5053.20160256
J. Braz. Chem. Soc. 2017, 28(6), 1030-1037
Development of a Dissolution Test for Fenbendazole-Praziquantel Capsules Using UV-PLS Method
Silvana E. Vignaduzzo; María A. Operto; Patricia M. Castellano
How to cite this article

The aim was to develop a dissolution test for fenbendazole-praziquantel capsules and an UV-PLS method for its evaluation.
https://dx.doi.org/10.21577/0103-5053.20160258
J. Braz. Chem. Soc. 2017, 28(6), 1038-1047
Preparative Separation and Structural Identification of Impurities of a New α2‑Adrenoceptor Agonist Using Stacking Injection, LC-MSn and LC-SPE-NMR
Josiane O. Cardoso; Sérgio S. Thomasi; Tiago Venâncio; Ivan R. Pitta; Maria do Carmo A. de Lima; Regina V. Oliveira
How to cite this article

A semi-preparative chromatography application and stacking injection for purification of drugs with high efficiency and lower consumption of solvents associated with liquid chromatography-multistage mass spectrometry (LC-MSn) and liquid chromatography-solid phase extraction-nuclear magnetic resonance (LC-SPE-NMR) techniques for structural characterization of impurities.
https://dx.doi.org/10.21577/0103-5053.20160259
J. Braz. Chem. Soc. 2017, 28(6), 1048-1062
Study of Reactions of Two Mannich Bases Derived of 4'-Hydroxychalcones with Glutathione by RP‑TLC, RP‑HPLC and RP‑HPLC‑ESI‑MS Analysis
Aline Bernardes; Caridad N. Pérez; Mátyás Mayer; Cameron C. da Silva; Felipe T. Martins; Pál Perjési
How to cite this article

Study on formation of GSH conjugation reaction of Mannich bases of 4'-hydroxylchalcones by RP-TLC, RP-HPLC and RP-HPLC-MS methods.
https://dx.doi.org/10.21577/0103-5053.20160260
J. Braz. Chem. Soc. 2017, 28(6), 1063-1073
Synthesis, Characterization and Dielectric Properties of New 5-(4-Hydroxyphenyl)-10,15,20-tri-4-[2-(3-pentadecylphenoxy)ethoxy]phenyl porphyrin and Their Ni, Co and Cu Complexes
Joao P. F. Mota; Antônio E. da Costa Júnior; Viviane G. P. Ribeiro; Samuel G. Sampaio; Nayane M. A. Lima; Fernando L. F. da Silva; Claudenilson S. Clemente; Giuseppe Mele; Diego Lomonaco; Selma E. Mazzetto
How to cite this article

Synthesis of a novel asymmetric porphyrin based on cardanol.
https://dx.doi.org/10.21577/0103-5053.20160261
J. Braz. Chem. Soc. 2017, 28(6), 1074-1080
Development and Characterization of Synthetic Chalcones-Loaded Eudragit RS 100 Microparticles for Oral Delivery
Cristian R. Kleemann; Talitha C. dos Santos; Luciana C. Tavares; Moacir G. Pizzolatti; Angela M. de Campos
How to cite this article

The study presents the development of a drug delivery system and validation of a simple and rapid high performance liquid chromatography method for the characterization of two chalcones in Eudragit® RS100-based microparticles
https://dx.doi.org/10.21577/0103-5053.20160263
J. Braz. Chem. Soc. 2017, 28(6), 1081-1090
Strategy for Correction of Matrix Effect on the Determination of Pesticides in Water Bodies Using SPME-GC-FID
Vitor P. A. Silva; Mário S. O. Paz; Rivelino M. Cavalcante; Ronaldo F. Nascimento
How to cite this article

Determination of pesticides in river water, estuarine, seawater and weir water using standard surrogate and relation factor by solid phase microextraction gas chromatography with flame ionization detector (SPME-GC-FID).
https://dx.doi.org/10.21577/0103-5053.20160264
J. Braz. Chem. Soc. 2017, 28(6), 1091-1097
Electrooxidation of Mixed Ethanol and Methanol Solutions on PtSn/C Electrocatalysts Prepared by the Polymeric Precursor Method
Aline Amorim; Luanna S. Parreira; Júlio César M. Silva; Mauro C. dos Santos
How to cite this article

PtSn/C (3:1) electrocatalyst for mixed solutions EtOH:MeOH oxidation can result the formation of CO2 at low potentials, as well as the highest amount of by-products than ethanol and methanol.
https://dx.doi.org/10.21577/0103-5053.20160266
J. Braz. Chem. Soc. 2017, 28(6), 1098-1105
Thermodynamic Feasibility of Pure Hydrogen Production and Storage in Iron and Germanium Based Double Chemical Looping Process
Grzegorz Słowiński; Adam Smoliński
How to cite this article

The idea of pure hydrogen production and storage in iron and germanium based double chemical looping process.
https://dx.doi.org/10.21577/0103-5053.20160267
J. Braz. Chem. Soc. 2017, 28(6), 1106-1112
Antitubercular Activity Increase in Labdane Diterpenes from Copaifera Oleoresin through Structural Modification
Aline N. Silva; Ana Carolina F. Soares; Mirela M. W. Cabral; Alex R. P. de Andrade; Marilza B. M. da Silva; Carlos H. G. Martins; Rodrigo C. S. Veneziani; Sérgio R. Ambrósio; Jairo K. Bastos; Vladimir C. G. Heleno
How to cite this article

Our work with natural diterpenes from Copaifera oilresin led to derivatives with remarkably increased anti-tubercular activity. Derivatives were obtained through synthetic structural modifications and their activities reached two, five and twenty-fold compared to natural precursors.
https://dx.doi.org/10.21577/0103-5053.20160268
J. Braz. Chem. Soc. 2017, 28(6), 1113-1122
Study of Viability of Solid-Phase Microextraction, in vivo, in the Extraction of Microbial Volatile Organic Compounds Associated to the Pigment Production Process by the Monascus Fungus, in Submerged Fermentation
Robson L. Schacker; Denise E. Moritz; Miguel S. B. Caro; Luiz A. S. Madureira; Adriana N. Dias; Josias O. Merib; Douglas Isfran; Eduardo Carasek
How to cite this article

Seventeen compounds were found associated with the presence of the Monascus fungus (in vivo solid phase microextraction (SPME)), the main being ethanol, 2-methyl-propanol, 3-methylbutanol, 2-methylbutanol and 2-phenylethanol, such compounds have been studied by empirical models.
https://dx.doi.org/10.21577/0103-5053.20160269
J. Braz. Chem. Soc. 2017, 28(6), 1123-1131
Ethylene Glycol Electro-Oxidation on Platinum-Free Surfaces: How the Composition of PdRuRh Surfaces Influences the Catalysis
Gisele A. B. Mello; Pedro H. B. Fernandes; Martha Janete de Giz; Giuseppe A. Camara
How to cite this article

Opposite to Pt, on PdRuRh catalysts CO2 is produced earlier than oxalic acid, and there is no self-inhibitory effect when EG concentration is increased.
https://dx.doi.org/10.21577/0103-5053.20160270
Short Report J. Braz. Chem. Soc. 2017, 28(6), 1132-1136
A New Prenylisoflavone from the Antifungal Extract of Leaves of Vatairea guianensis Aubl.
Ronilson F. Souza; Geilson A. da Silva; Alberto C. Arruda; Milton N. da Silva; Alberdan S. Santos; Daniella P. A. Grisólia; Moises B. Silva; Claudio G. Salgado; Mara Silvia P. Arruda
How to cite this article

One new isoflavone, in addition to two known ones were isolated from the leaves of Vatairea guianensis Aubl. (Fabaceae). The extract, AcOEt fraction and two isolated compounds exhibited antifungal activity through in vitro testing.
https://dx.doi.org/10.21577/0103-5053.20160250
J. Braz. Chem. Soc. 2017, 28(6), 1137-1144
Eco-Friendly, Catalyst and Solvent-Free, Synthesis of Acetanilides and N-Benzothiazole-2-yl-acetamides
Silvio Cunha; Lourenço L. B. de Santana
How to cite this article

An expeditious and green synthesis of acetamides is described in good yield without external heating, and with simple purification.
This paper is part of the PubliSBQ Special Issue in honor of the late Prof Angelo da Cunha Pinto.
https://dx.doi.org/10.21577/0103-5053.20160265
Online version ISSN 1678-4790 Printed version ISSN 0103-5053
Journal of the Brazilian Chemical Society
JBCS Editorial and Publishing Office
University of Campinas - UNICAMP
13083-970 Campinas-SP, Brazil
Free access










